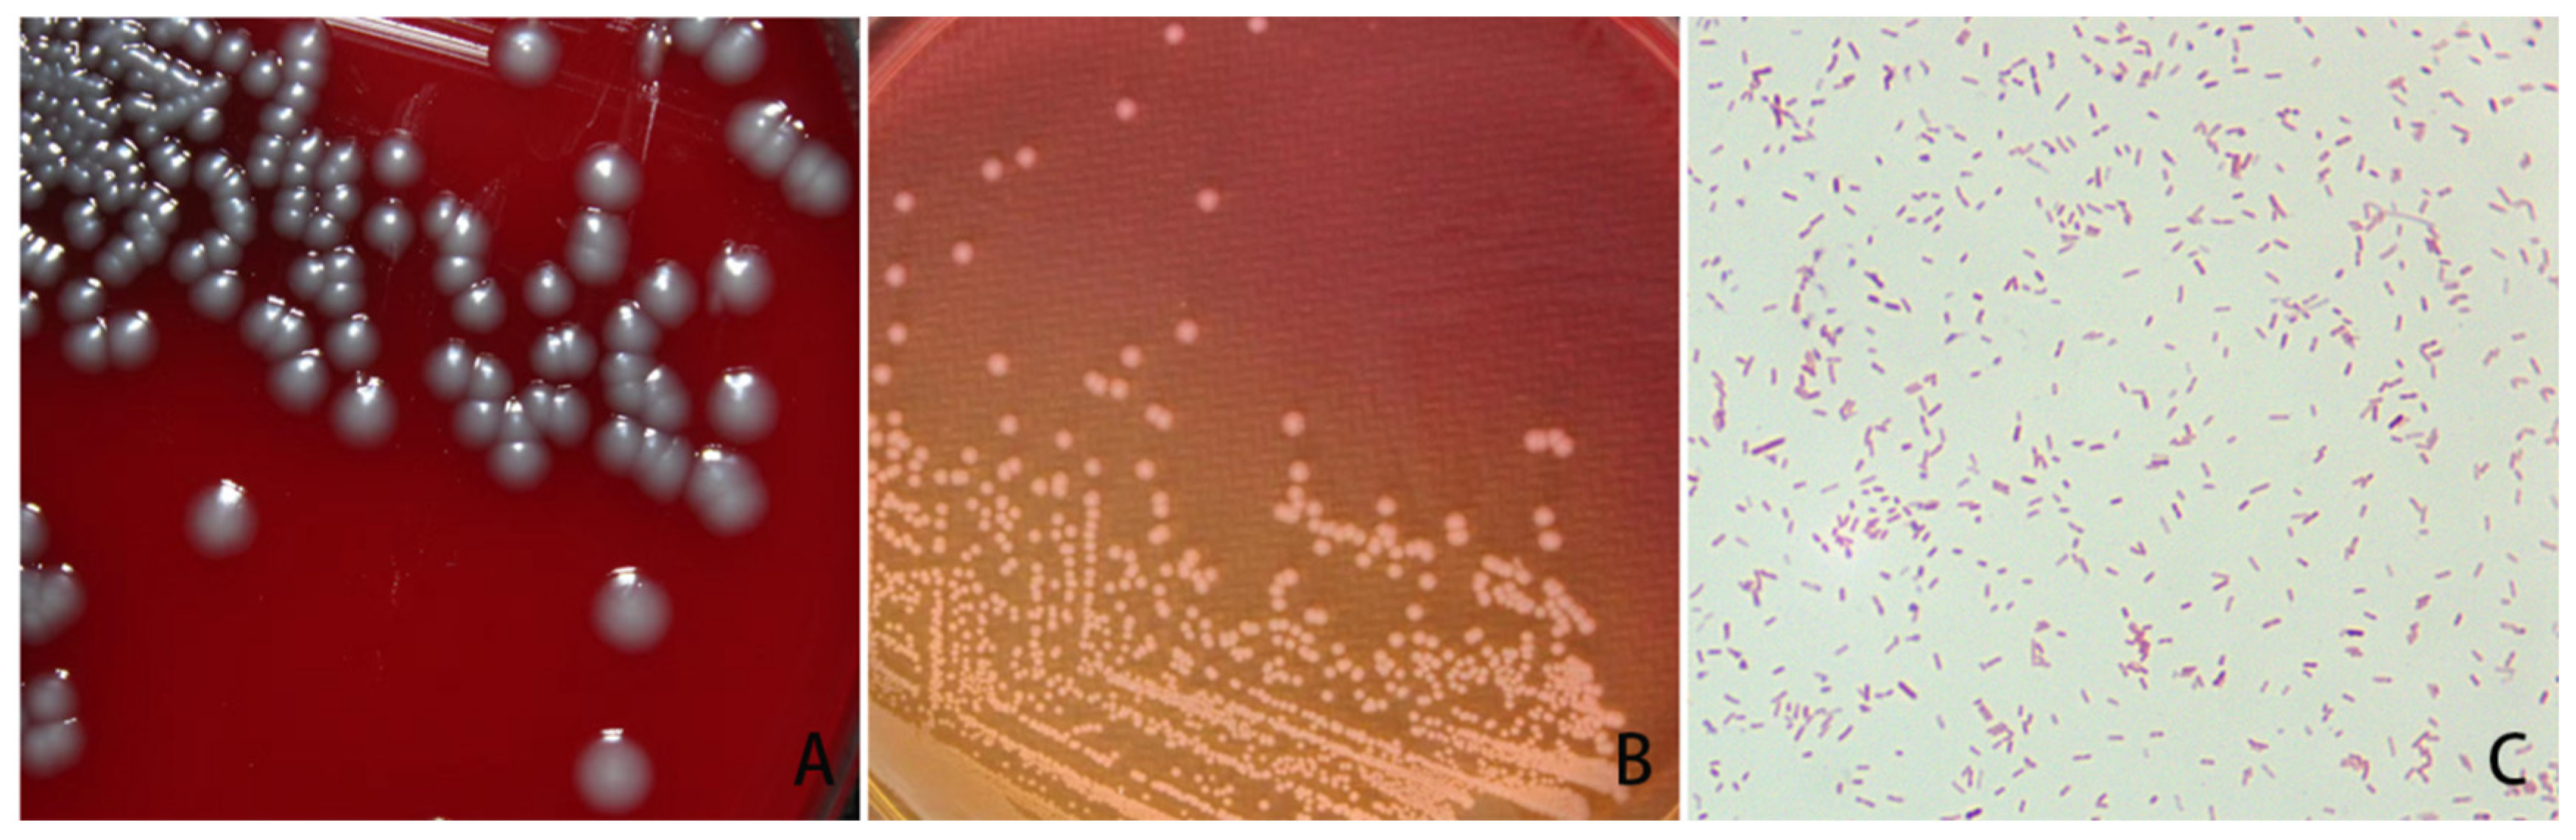
Vetsci 11 00223 g001

Isolation and Identification of Morganella morganii from Rhesus Monkey (Macaca mulatta) in China
Abstract
Simple Summary
Abstract
1. Introduction
2. Materials and Methods
2.1. Samples
2.2. Bacterial Isolation and Morphological Observation
2.3. Amplification and Sequencing of Bacterial 16S rRNA
2.4. Sequence Alignment and Phylogenetic Tree Construction
2.5. Antibiotic Sensitivity Testing
3. Results
4. Discussion
5. Conclusions
Author Contributions
Funding
Institutional Review Board Statement
Informed Consent Statement
Data Availability Statement
Acknowledgments
Conflicts of Interest
References
- Thippeshappa, R.; Kimata, J.T.; Kaushal, D. Toward a macaque model of HIV-1 infection: Roadblocks, progress, and future strategies. Front. Microbiol. 2020, 11, 882. [Google Scholar] [CrossRef]
- Shao, Y.; Zheng, Y.; Zhang, J.; Wei, L.; Tian, Y.; Sun, G.; Liu, Y.; Luo, Y.; Gu, X. Study on the anti-inflammatory effect of leonurine on IPS-induced endometritis in mice. Chin. Anim. Husb. Vet. Med. 2023, 50, 2149–2155. [Google Scholar]
- Agrawal, K.U.; Joshi, K.L.; Gad, M. A rare case of fulminant acute postoperative Morganella morganii endophthalmitis. Ocul. Immunol. Inflamm. 2023, 31, 123–126. [Google Scholar] [CrossRef] [PubMed]
- Huang, W.H.; Kao, C.C.; Mao, Y.C.; Lai, C.S.; Lai, K.L.; Lai, C.H.; Tseng, C.H.; Huang, Y.T.; Liu, P.Y. Shewanella algae and Morganella morganii coinfection in cobra-bite wounds: A genomic analysis. Life 2021, 11, 329. [Google Scholar] [CrossRef]
- Lin, W.H.; Tsai, T.S.; Chuang, P.C. The presence of four pathogenic oral bacterial species in six wild snake species from southern Taiwan: Associated factors. Microorganisms 2024, 12, 263. [Google Scholar] [CrossRef] [PubMed]
- Park, S.Y.; Lee, K.; Cho, Y.; Lim, S.R.; Kwon, H.; Han, J.E.; Kim, J.H. Emergence of third-generation cephalosporin-resistant Morganella morganii in a captive breeding dolphin in south Korea. Animals 2020, 10, 2052. [Google Scholar] [CrossRef]
- Yamaki, S.; Sakanoue, A.; Arai, K.; Yamazaki, K.; Kawai, Y. Inhibition of Morganella morganii growth and histamine production using a bacteriophage cocktail. Food Sci. Technol. Res. 2022, 28, 489–499. [Google Scholar] [CrossRef]
- Li, G.; Niu, X.; Yuan, S.; Liang, L.; Liu, Y.; Hu, L.; Liu, J.; Cheng, Z. Emergence of Morganella morganii subsp morganii in dairy calves, China. Emerg. Microbes Infect. 2018, 7, 172. [Google Scholar] [CrossRef] [PubMed]
- Zaric, R.Z.; Jankovic, S.; Zaric, M.; Milosavljevic, M.; Stojadinovic, M.; Pejcic, A. Antimicrobial treatment of Morganella morganii invasive infections: Systematic review. Indian J. Med. Microbiol. 2021, 39, 404–412. [Google Scholar] [CrossRef]
- Liu, H.; Zhu, J.; Hu, Q.; Rao, X. Morganella morganii, a non-negligent opportunistic pathogen. Int. J. Infect. Dis. 2016, 50, 10–17. [Google Scholar] [CrossRef]
- Xiang, G.X.; Lan, K.; Cai, Y.M.; Liao, K.; Zhao, M.; Tao, J.; Ma, Y.; Zeng, J.M.; Zhang, W.Z.; Wu, Z.W.; et al. Clinical molecular and genomic epidemiology of Morganella morganii in China. Front Microbiol. 2021, 12, 744291. [Google Scholar] [CrossRef] [PubMed]
- Behera, D.U.; Dixit, S.; Gaur, M.; Mishra, R.; Sahoo, R.K.; Sahoo, M.; Behera, B.K.; Subudhi, B.B.; Bharat, S.S.; Subudhi, E. Sequencing and characterization of M. morganii strain UM869: A comprehensive comparative genomic analysis of virulence, antibiotic resistance, and functional pathways. Genes 2023, 14, 1279. [Google Scholar] [CrossRef]
- Katz, L.M.; Lewis, R.J.; Borenstein, D.G. Successful joint arthroplasty following proteus morganii (Morganella morganii) septic arthritis: A four-year study. Arthritis Rheum. 1987, 30, 583–585. [Google Scholar] [CrossRef] [PubMed]
- Laupland, K.B.; Paterson, D.L.; Edwards, F.; Stewart, A.G.; Harris, P.N. Morganella morganii, an emerging cause of bloodstream infections. Microbiol. Spectr. 2022, 10, e0056922. [Google Scholar] [CrossRef] [PubMed]
- Renee, V.B.; Judith, N.; Estherde, D.W.; Hoogendoorn, M.H. Native aortic valve endocarditis with Morganella morganii in a patient with multiple myeloma and valvular amyloidosis: A case report. BMC Infect. Dis. 2019, 19, 957. [Google Scholar]
- Vijaya, D.; Sathish, J.V.; Yashaswini, M.K.; Sulaiman, S. Morganella morganii causing abscess over the anterior chest wall—A case report. J. Clin. Diagn. Res. JCDR 2014, 8, DD03. [Google Scholar] [CrossRef]
- Livani, F.; Kabir, S. Gram-negative folliculitis caused by Morganella morganii. JAAD Case Rep. 2019, 5, 558–559. [Google Scholar] [CrossRef]
- Zhu, L.; Zhang, S.; Yang, S.; Zhan, J.; Li, Z.; Liu, D.; Wang, S.; Yao, J. Isolation and identification of Morganella morganii from piglets with diarrhea. Chin. J. Vet. Med. 2021, 57, 38–42. [Google Scholar]
- Holasoo, H.R.; Tamai, I.A.; Bruck, W.M.; Pakbin, B.; Nasiri, A.; Azizi, A. Morganella Morganii infection in Hirudo medicinalis (Iran): A case report. Vet. Sci. 2022, 9, 562. [Google Scholar] [CrossRef]
- Wei, D.; Xiao, S.; Liao, W.; Yu, Q.; Han, S.; Shi, J.; He, J.; Li, P. The occurrence of Morganella morganii caused large death in cultured American bullfrog (Rana catebeiana). Aquaculture 2023, 568, 739343. [Google Scholar] [CrossRef]
- Hu, Y.; Ma, J.; Bai, S.; Zhai, Y.; Liu, J.; Song, H.; Yang, Y. Isolation, identification and biological characteristics analysis of Morganella morganii from endometritis of south China tiger (Panthera tigris amoyensis). Chin. Anim. Husb. Vet. Med. 2023, 50, 1271–1278. [Google Scholar]
- Rahman, A.; Bhuiyan, O.F.; Sadique, A.; Afroze, T.; Sarker, M.; Momen, A.M.; Alam, J.; Hossain, A.; Khan, I.; Rahman, K.F.; et al. Whole genome sequencing provides genomic insights into three Morganella morganii strains isolated from bovine rectal swabs in Dhaka, Bangladesh. FEMS Microbiol. Lett. 2020, 367, fnaa043. [Google Scholar] [CrossRef] [PubMed]
- Singh, N.; Sethi, A. Endometritis—Diagnosis, treatment and its impact on fertility—A scoping review. JBRA Assist. Reprod. 2022, 26, 538–546. [Google Scholar] [CrossRef]
- Shah, H.U.; Sannananja, B.; Baheti, A.D.; Udare, A.S.; Badhe, P.V. Hysterosalpingography and ultrasonography findings of female genital tuberculosis. Diagn. Interv. Radiol. 2015, 21, 10–15. [Google Scholar] [CrossRef] [PubMed]
- Jalandra, R.; Dalal, N.; Mohan, A.; Solanki, P.R.; Kumar, A. A novel method for enrichment of Morganella morganii in fecal samples using designed culture medium. Cell Biochem. Funct. 2024, 42, e4004. [Google Scholar] [CrossRef] [PubMed]
- Luo, X.; Liu, P.; Miao, Q.; Han, R.; Wu, H.; Liu, J.; He, D.; Hu, G. Multidrug resistance genes carried by a novel transposon Tn7376 and a genomic island named MMGI-4 in a pathogenic Morganella morganii isolate. Microbiol. Spectr. 2022, 10, e0026522. [Google Scholar] [CrossRef] [PubMed]
- Behera, D.U.; Ratnajothy, K.; Dey, S.; Gaur, M.; Sahoo, R.; Sahoo, S.; Rautaraya, B.; Rout, M.; Subudhi, E. In vitro synergistic interaction of colistin and other antimicrobials against intrinsic colistin-resistant Morganella morganii isolates. 3 Biotech 2023, 13, 127. [Google Scholar] [CrossRef]

| Antibiotics (Medication Dose: µg/tablet) | IZD (mm) | Sensitivity | Judgment Standard of Inhibition Zone Diameter (mm) | ||
|---|---|---|---|---|---|
| Resistant | Medium Sensitivity | Highly Sensitive | |||
| Penicillin (10) | 0 | R | ≤14 | — | ≥15 |
| Ceftriaxone (30) | 30 | S | ≤13 | 14–22 | ≥23 |
| Amikacin (30) | 20 | S | ≤14 | 15–16 | ≥17 |
| Gentamicin (10) | 18 | S | ≤12 | 13–14 | ≥15 |
| Ampicillin (10) | 14 | I | ≤13 | 14–16 | ≥17 |
| Cefazolin (30) | 22 | S | ≤14 | 15–17 | ≥18 |
| Cefuroxime (30) | 20 | S | ≤16 | 17–19 | ≥20 |
| Ceftazidime (30) | 28 | S | ≤17 | 18–20 | ≥21 |
| Levofloxacin (5) | 22 | S | ≤13 | 14–16 | ≥17 |
| Vancomycin (30) | 0 | R | ≤9 | 10–11 | ≥12 |
| Cotrimoxazole (23.75) | 20 | S | ≤10 | 11–15 | ≥16 |
| Ciprofloxacin (5) | 24 | R | ≤27 | 28–40 | ≥41 |
| Norfloxacin (10) | 24 | S | ≤12 | 13–16 | ≥17 |
| Clindamycin (2) | 0 | R | ≤14 | 15–20 | ≥21 |
| Tetracycline (30) | 24 | S | ≤14 | 15–18 | ≥19 |
Disclaimer/Publisher’s Note: The statements, opinions and data contained in all publications are solely those of the individual author(s) and contributor(s) and not of MDPI and/or the editor(s). MDPI and/or the editor(s) disclaim responsibility for any injury to people or property resulting from any ideas, methods, instructions or products referred to in the content. |
© 2024 by the authors. Licensee MDPI, Basel, Switzerland. This article is an open access article distributed under the terms and conditions of the Creative Commons Attribution (CC BY) license (https://creativecommons.org/licenses/by/4.0/).
Share and Cite
Li, H.; Chen, Z.; Ning, Q.; Zong, F.; Wang, H. Isolation and Identification of Morganella morganii from Rhesus Monkey (Macaca mulatta) in China. Vet. Sci. 2024, 11, 223. https://doi.org/10.3390/vetsci11050223
Li H, Chen Z, Ning Q, Zong F, Wang H. Isolation and Identification of Morganella morganii from Rhesus Monkey (Macaca mulatta) in China. Veterinary Sciences. 2024; 11(5):223. https://doi.org/10.3390/vetsci11050223
Chicago/Turabian StyleLi, Heling, Zhigang Chen, Qing Ning, Faliang Zong, and Hong Wang. 2024. "Isolation and Identification of Morganella morganii from Rhesus Monkey (Macaca mulatta) in China" Veterinary Sciences 11, no. 5: 223. https://doi.org/10.3390/vetsci11050223
APA StyleLi, H., Chen, Z., Ning, Q., Zong, F., & Wang, H. (2024). Isolation and Identification of Morganella morganii from Rhesus Monkey (Macaca mulatta) in China. Veterinary Sciences, 11(5), 223. https://doi.org/10.3390/vetsci11050223

